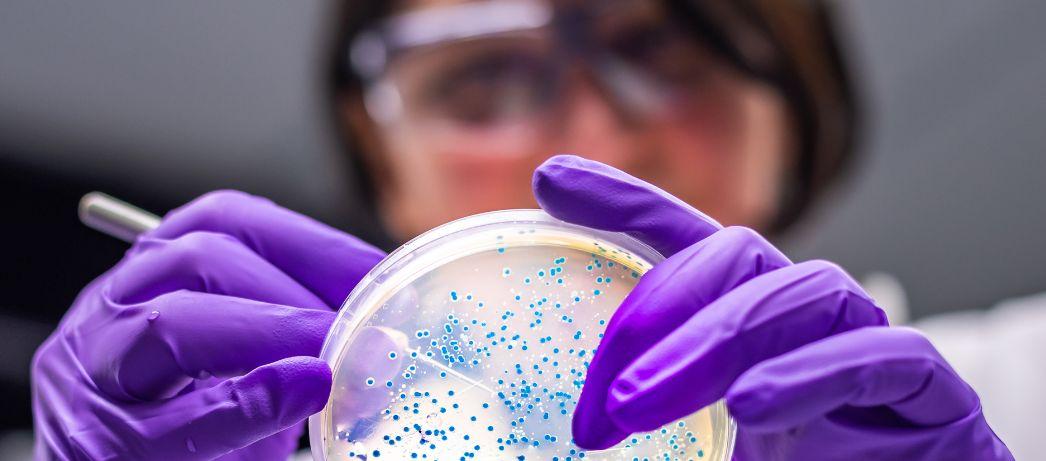
Female veterinarian performing examination of bacterial culture plate

Department of Pathobiology
About
The Department of Pathobiology is dedicated to the advancement of knowledge in veterinary and comparative pathology, veterinary infectious diseases and immunology. Our faculty members’ research ranges from the basic understanding of the mechanisms of disease caused by a wide range of agents (including emerging and zoonotic pathogens) to the different protective and pathological responses to host organisms. We offer advanced training in diagnostic anatomic and clinical pathology, as well as research training in our areas of expertise.
Core Areas of Emphasis
- Mammalian Pathology
- Comparative Pathology
- Veterinary Infectious Disease
- Microbiology
- Immunology
- Public Health
Academics & Research Information

Contact Us
Department of Pathobiology
Ontario Veterinary College
University of Guelph
50 Stone Road East, Guelph, Ontario, Canada, NIG 2W1
Main Office Reception - Room 3840, 519-824-4120 ext 54755
Building Hours
Monday - Friday: 7:30am -6:00pm





